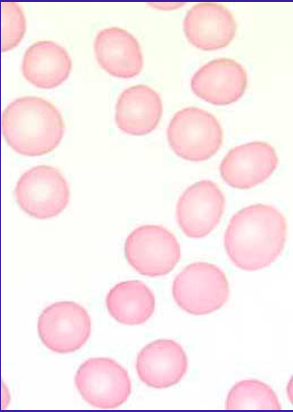
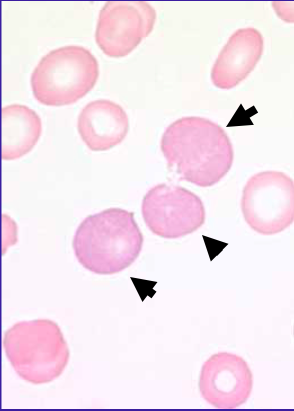
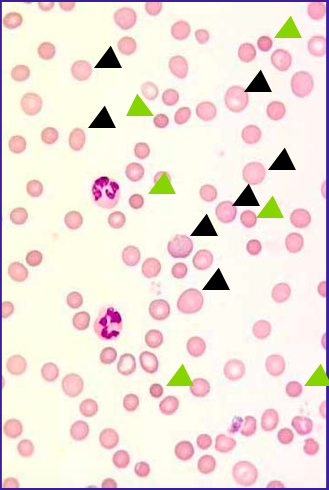
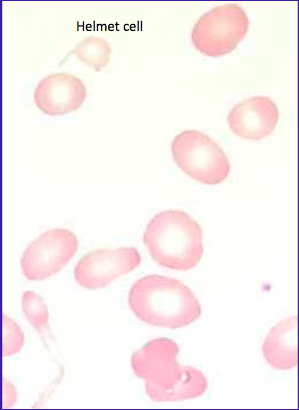
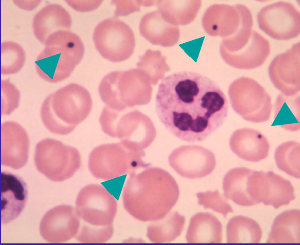
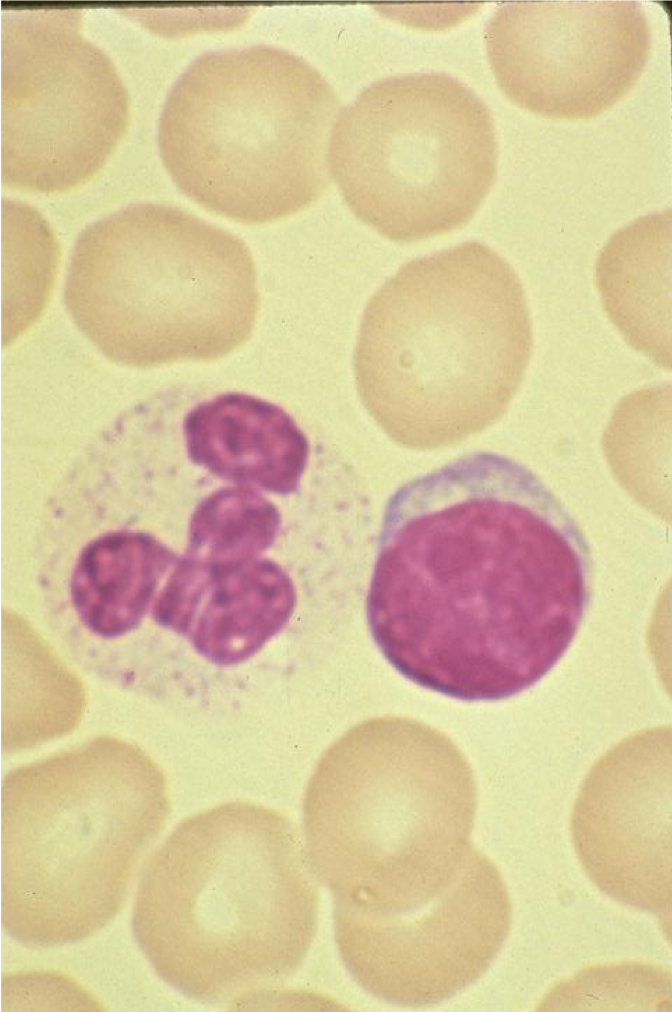
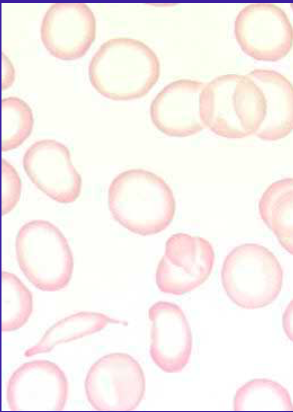
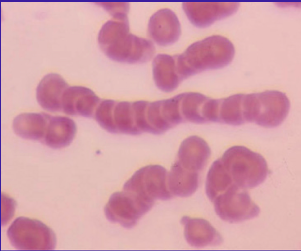
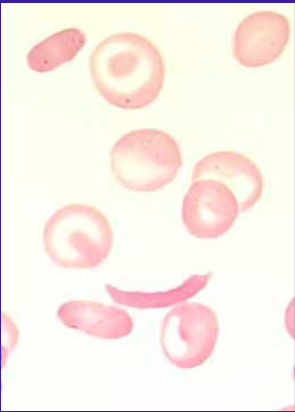

Mean Corpuscle Volume (MCV)
Spherocytes
If a patient has Howell-Jolly bodies after a splenectomy and then later is tested and does not have them, what could have occurred?
Acanthocytes

Polychromasia refers to
Red cells that have a more bluish tinge
If you see these cells, then it is an emergency and fatal in 80% of cases if left untreated after a few hours
** MAHA
If due to autoimmune hemolysis, the spherocytes are
What would you use to measure hypochromasia?
In normal peripheral blood, what cell types should be present?
WBCs, RBCs, and platelets
Differential diagnoses of macrocytosis
When looking at a blood smear, what part are we interested in looking at for diagnostic purposes?
The feathered edge

Megaloblastic anemia

Autoimmune Hemolytic Anemia (AIHA)
Poikolocytosis refers to
Howell- Jolly Bodies
Echinocytes

The overarching term for red cells that vary widely in size
-Anisocytosis
Most common cause of microcytosis
Iron deficiency anemia
A normal RBC should be about the size of
A lymphocyte nucleus
What lab value can you use to determine macrocytosis?
MCV
Hypochromasia refers to
Rouleaux
Which type of process should you think of when see spherocytes?
Sickle cells are seen in which condition?